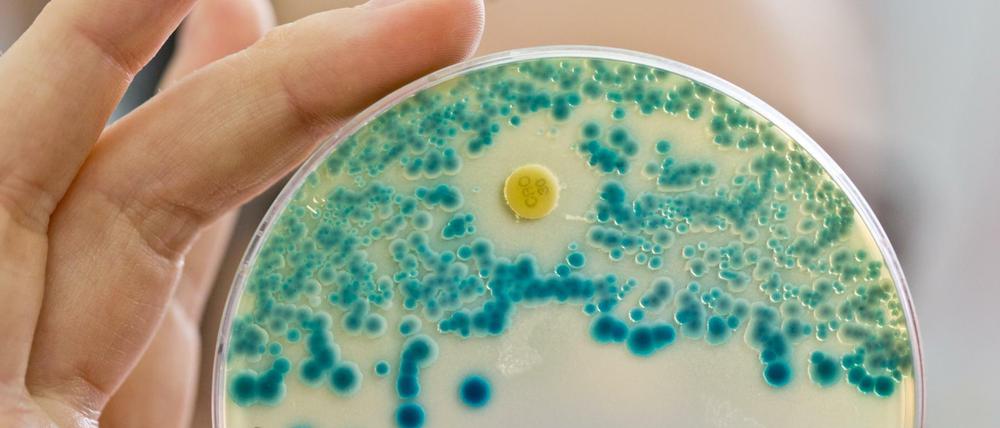
Eine Indikatorkulturplatte zum Nachweis von resistenten Bakterien.

© Daniel Karmann/dpa
Antibiotika-Resistenz: Resistenz gegen Notfall-Therapie auch in USA nachgewiesen
Erstmals ist der "Super"-Erreger auch in den USA festgestellt worden. Das Bakterium ist gegen jedes Antibiotikum resistent.
Stand:
In Deutschland bereits nachgewiesene und gegen das Notfall-Antibiotikum Colistin resistente Bakterien sind nun auch in den USA aufgetaucht. Das für die Resistenz verantwortliche Gen mcr-1 sei in einer Bakterienprobe einer 49-Jährigen aus Pennsylvania entdeckt worden, schreiben Forscher im Fachblatt „Antimicrobial Agents and Chemotherapy“. Colistin kommt zum Einsatz, wenn verbreitete Antibiotika nicht mehr helfen.
Im Januar hatte das deutsche Bundesinstitut für Risikobewertung (BfR) berichtet, dass das Gen mcr-1 in Bakterienproben von Menschen nachgewiesen worden und bei Nutztieren weit verbreitet sei.
Das Gen macht insbesondere Darmbakterien gegen Colistin resistent. Das Medikament wurde nach Angaben des Robert Koch-Instituts (RKI) in den vergangenen Jahren wieder häufiger verwendet. Es diene als „eine letzte verbliebene Therapieoption“.
Als kritisch bewerten Experten, dass das Resistenz-Gen mcr-1 zwischen Bakterienstämmen übertragbar ist - im Gegensatz zu bisher bekannten Colistin-Resistenzen. Es kann von harmlosen Darmkeimen auf Krankheitserreger übergehen und die Behandlung gegen diese erschweren. Die Direktorin der Weltgesundheitsorganisation WHO, Margaret Chan, sprach im Februar von einer Krise globalen Ausmaßes. (dpa)
- showPaywall:
- false
- isSubscriber:
- false
- isPaid: